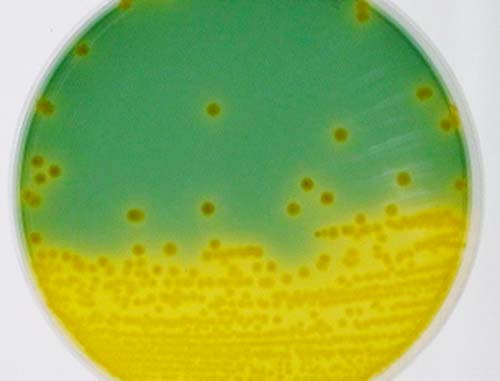
TCBS培地上のVibrio fluvialisのコロニー写真。培地の下半分は黄色く変色しており、上半分は緑色の背景に黄色い円形のコロニーが散在している。

ビブリオ・フルビアリス/ファーニシ感染症
更新作業中のため、ページの一部に古い情報が含まれる場合があります。
Vibrio fluvialisはFurnissらにより1977年バーレーンではじめて発見され、ビブリオ属とエロモナス属に近いがどちらにも分類できず、当初、グループFビブリオと呼ばれた。さらに、バングラデシュで500人以上の下痢症集団発生事例から同様の菌が分離され(Huq et al.,1980)、グループEF‐6ビブリオと呼ばれ下痢症の原因菌として説明されたことから、以来下痢患者便からの分離報告例が見られるようになった。その後Leeらにより新しい菌種として提案され、V.fluvialisと命名された。
一方、V.furnissiiはもともとV.fluvialisのガス産生株として考えられていたが、1983年BrennerらのDNA相同性試験の結果により、V.fluvialisとは異なる独立した菌種として分類されるようになった。
疫学
Vibrio fluvialisおよびV.furnissiiは腸炎ビブリオなどと同様海水細菌の一種で、河口域、沿岸地域に広く分布している。河川水、海水および沿岸の泥土等の環境材料、また魚介類の汚染も高率で、これらが感染源になっていると考えられている(表1)。
V.fluvialisによる下痢症はこれまで、中東、インド、バングラデシュ、アメリカ合衆国のフロリダ州、ルイジアナ州などのメキシコ湾沿岸地域での報告が多い。患者の約20%が5歳以下の小児であるが、全体的に患者の年齢は幅広く大きな偏りはない。これらの下痢患者は生ガキやエビなど海産物の喫食、もしくは菌に汚染された飲料水の摂取が疑われるものが多く、それらが感染源となっていると考えられている。また乳児や、糖尿病、アルコール依存症、潰瘍性大腸炎やエイズなどの基礎疾患を持つ患者の例も報告されている。しかし本菌による死亡例の報告は少なく、赤痢菌との混合感染による菌血症、心冠状動脈障害の合併、吐物の誤飲などによる。我が国では海外旅行者による輸入散発下痢症例が主で、そのほとんどが腸炎ビブリオとの混合感染であり、V.fluvialisの単独感染例は少ない。
V.furnissiiに関する事例報告も少なく、V.fluvialisと同様に腸炎ビブリオなどとの混合感染例がほとんどで、本菌と下痢症との関連性は明らかではなかった。しかし、1997年Dalsgaardらがペルーの下痢患者およびその家族などからV.furnissiiのみを分離したと報告しており、本菌も下痢症の原因菌と考えられるようになった。
| 検体 | 全検体数 | 陽性検体数(陽性率%) |
|---|---|---|
| 海水 | 38 | 22(57.9) |
| 汚水 | 46 | 14(30.4) |
| 河川水 | 8 | 1(12.5) |
| 冷凍エビ類 | 24 | 17(70.8) |
| 刺身 | 28 | 15(53.6) |
| 貝類 | 13 | 4(30.8) |
| 下痢患者便 | 1,462 | 3(0.2) |
| 健常者便 | 1,709 | 0 |
小林、1983 感染症学誌より抜粋、改変
病原体
V.fluvialisはコレラ菌、腸炎ビブリオと同じビブリオ属菌であり、グラム陰性の短桿菌で一端に一本の鞭毛を持ち、活発に運動する(図1)。オキシダーゼ陽性で、アミノ酸脱炭酸等生化学的性状がエロモナス属と類似しているが、好塩性で6~7%NaCl濃度でも増殖できる。病原因子については、赤痢菌属のような細胞侵入性はなく、接着因子についてもほとんど不明であるが、易熱性毒素や溶血毒の存在が報告されており、下痢の発現に関係するものと考えられている。
V.furnissiiの性状はV.fluvialisとほとんど同じであるが、ブドウ糖分解により前者がガスを産生するのに対し、後者はガスを産生しない点で区別される。

図1.V.fluvialisの電子顕微鏡写真(40,000倍)
図2.TCBS培地上のV.fluvialis
臨床症状
V.fluvialisおよびV.furnissiiによる下痢症では、半日~数日間の潜伏期間の後、水様性下痢と嘔吐、腹痛等を主訴として発症するが、小児や高齢者では中等度の脱水をみることがあるので注意が必要である。下痢は通常数日から1週間ほど続くが、重症例はまれで予後は良好である。発熱や白血球増加をみることもあるが、必発ではない。ときに血便をみることがあり、患者便の約75%に赤血球および白血球が混入していたとする報告もある(Huq et al.、1980)。
胃腸炎以外の感染例はきわめてまれで、外傷や医療用ヒルからの創傷感染、急性化膿性胆道炎などが報告されている。
病原診断
確定診断は患者便からの菌の検出による。
菌の分離方法は腸炎ビブリオと同様で、便を直接もしくは1%NaCl加アルカリペプトン水にて増菌した後、TCBS培地に塗布し、35~37℃で一晩培養する。
V.fluvialis、V.furnissiiともに、TCBS上でコレラ菌などと同様に直径約2mmの白糖分解性の黄色コロニーを形成する(図2)。これをさらにTSI、LIM等の確認培地に接種して同定を行う。そのキー性状は(1)好塩性試験、および、1%NaCl加培地を用いた(2)VP反応、(3)アミノ酸脱炭酸、(4)ブドウ糖からのガス産生、などである(表2)。

治療・予防
治療は対症療法が基本となり、特に脱水症状が懸念される時には経口または静脈内輸液を行う。抗菌薬治療は年少者や高齢者、何らかの基礎疾患を有するハイリスク患者以外は原則として必要ではないが、必要な場合はテトラサイクリン、ドキシサイクリン、セフォタキシム等が有効である。
予防は一般の細菌性食中毒と同様であり、特に魚介類の生食に注意すべきである。さらに冷凍輸入エビから高率に検出されたという報告もあり、これら汚染のおそれのある魚介類からの調理食品への二次汚染を防止する。
食品衛生法での取り扱い
食中毒が疑われる場合は、24時間以内に最寄りの保健所に届け出る。
(大阪府立公衆衛生研究所公衆衛生部 河原隆二 小林一寛)

